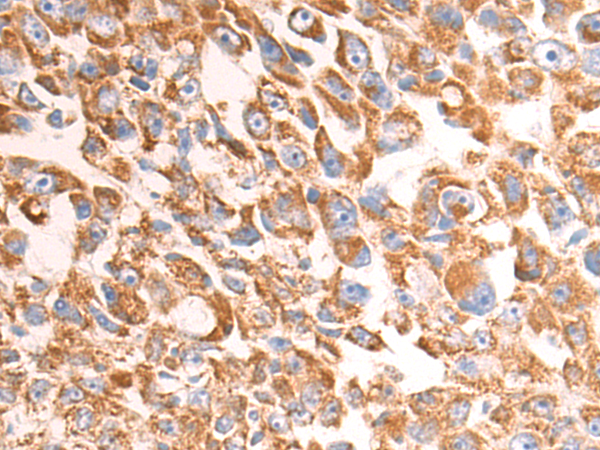

别名:AIF; AUNX1; CMT2D; CMTX4; COWCK; DFNX5; NADMR; NAMSD; PDCD8; COXPD6; SEMDHL应用:WB,IHC
反应种属:Human, Mouse, Rat
规格:50μl/100μl
| Description |
|---|
| This gene encodes a flavoprotein essential for nuclear disassembly in apoptotic cells, and it is found in the mitochondrial intermembrane space in healthy cells. Induction of apoptosis results in the translocation of this protein to the nucleus where it affects chromosome condensation and fragmentation. In addition, this gene product induces mitochondria to release the apoptogenic proteins cytochrome c and caspase-9. Mutations in this gene cause combined oxidative phosphorylation deficiency 6 (COXPD6), a severe mitochondrial encephalomyopathy, as well as Cowchock syndrome, also known as X-linked recessive Charcot-Marie-Tooth disease-4 (CMTX-4), a disorder resulting in neuropathy, and axonal and motor-sensory defects with deafness and cognitive disability. Alternative splicing results in multiple transcript variants. A related pseudogene has been identified on chromosome 10. |
| Specification | |
|---|---|
| Aliases | AIF; AUNX1; CMT2D; CMTX4; COWCK; DFNX5; NADMR; NAMSD; PDCD8; COXPD6; SEMDHL |
| Swissprot | O95831 |
| WB Predicted band size | 67 kDa |
| Host/Isotype | Rabbit IgG |
| Storage | Store at 4°C short term. Aliquot and store at -20°C long term. Avoid freeze/thaw cycles. |
| Species Reactivity | Human, Mouse, Rat |
| Immunogen | Fusion protein of human AIFM1 |
| Formulation | pH7.4 PBS, 0.05% NaN3, 40% Glycerol |
| Application | |
|---|---|
| WB | 1/1000-1/5000 |
| IHC | 1/100-1/300 |
| ELISA | 1/5000-1/10000 |
![]() |
Gel: 8%SDS-PAGE, Lysate: 40 μg, Lane 1-5: Hela, A549, MCF7, HepG2, K562 cell lysates, Primary antibody: P07069(AIFM1 Antibody) at dilution 1/1600, Secondary antibody: Goat anti rabbit IgG at 1/5000 dilution, Exposure time: 1 second |
![]() |
The image is immunohistochemistry of paraffin-embedded Human liver cancer tissue using P07069(AIFM1 Antibody) at dilution 1/120. (Original magnification: ×200) |
![]() |
The image is immunohistochemistry of paraffin-embedded Human breast cancer tissue using P07069(AIFM1 Antibody) at dilution 1/120. (Original magnification: ×200) |
本公司的所有产品仅用于科学研究或者工业应用等非医疗目的,不可用于人类或动物的临床诊断或治疗,非药用,非食用。
暂无评论
本公司的所有产品仅用于科学研究或者工业应用等非医疗目的,不可用于人类或动物的临床诊断或治疗,非药用,非食用。
中文

发表回复